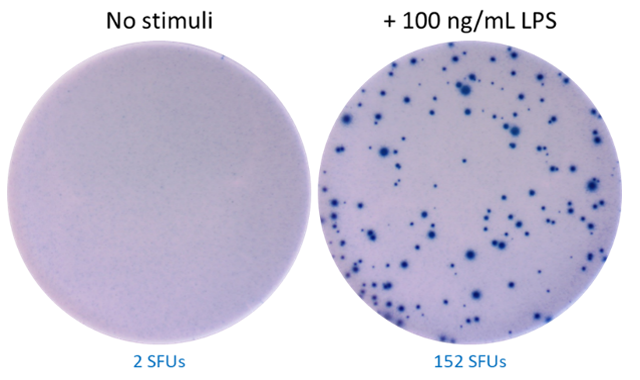
ELISpot MAX(TM) Deluxe Set Human IL-6 Reactivity: Human Size: 5 plate

Gauss
ELISpot MAX(TM) Deluxe Set Human IL-6 Reactivity: Human Size: 5 plate
Réf.
UGAP : 4336656
Réf.
Fournisseur : 430524
Réf.
Constructeur : 430524
Franco de port et d'emballage pour toutes les commandes supérieures à 80€ HT.
Produit ni repris ni échangé excepté en cas d’erreur du prestataire.
Garantie
Garantie 0 Mois
Caractéristiques
- Fournisseur
- BioLegend Europe BV
- Marque
- BIOLEGEND
- Référence distributeur
- 430524
- Référence fabricant
- 430524
- Code à barre
- oui
- Domaine de recherche
- biologie cellulaire
- Type d'échantillon
- cellule
- Lieu de fabrication
- États-Unis
- Type de produit
- kit
- Certification
- RUO
- Soumis à carboglace
- non
- Température de conservation (°C)
- 4 °C
- Température de transport
- ambiante
- Organisme cible
- humain
- Quantité
- N/A
- Matière dangereuse
- non
- Code douanier
- 3822190080
- Reprise en cas d’erreur client
- non
- Nomenclature Nacres
- NA.84
- Nomenclature CEA
- SGP01
- Nomenclature IRSN
- 273
- Nomenclature INSERM
- NA.NA84
- Nomenclature CNRS
- NA84
- Nomenclature CHU
- 18.551
- Nomenclature DGOS
- LD11AOOO